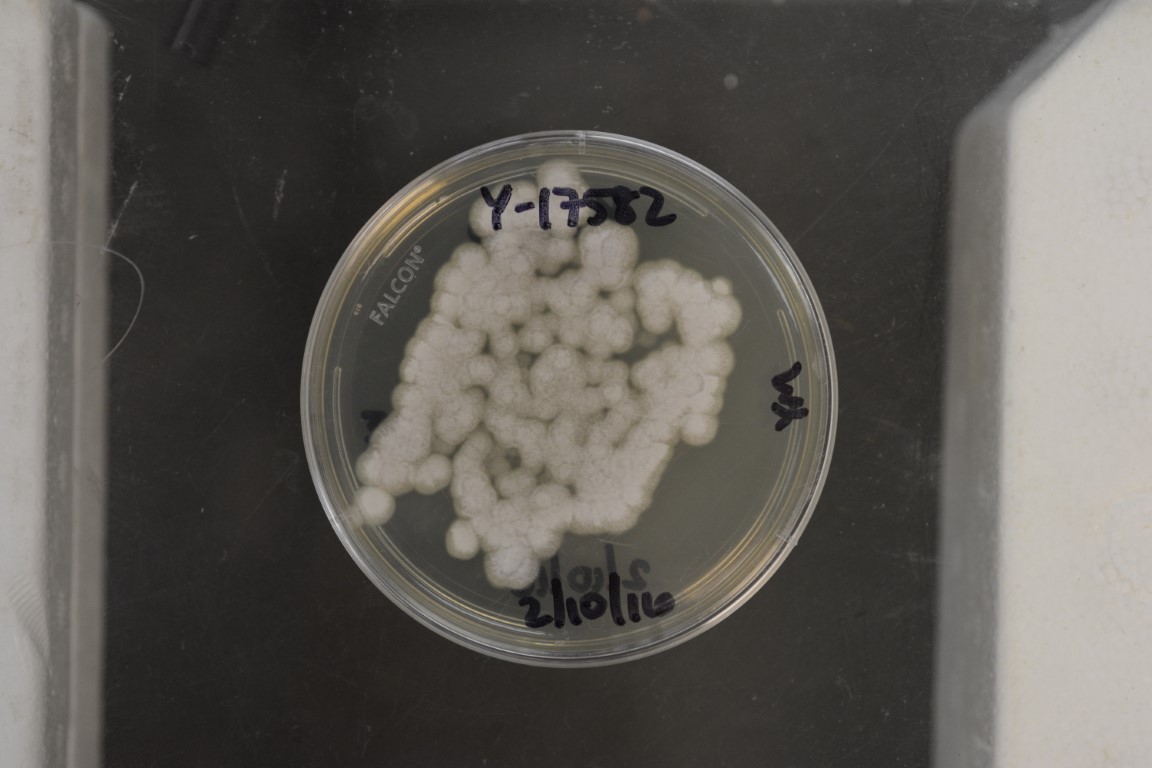

Eremothecium cymbalariae
NRRL Y-17582(Type Strain)
Accession numbers in other collections:CBS 270.75
Source:de Hoog,CBS,Baarn,The Netherlands
Isolated from(substrate):IN,plant pathogenic insect,Brachynema germari
Substrate location:Iran
Genetic info:Robnett PCR#22,#115.GenBank:D1/D2(U43388),SSU(AY046268),ITS(AY046219),mit SSU(AF442352),COXII(AF442276),EF-1 alpha(AF402090).
Growth media:Yeast Extract-Malt Extract-Peptone-Glucose(YM for yeasts)(number 6)
Optimum growth temperature:25C
Strain images:
NRRL_Y-17582_6.jpg

Comments:Neotype strain.Authentic strain(no designated type strain).
This strain is a regulated plant pathogen.An APHIS PPQ 526 permit is required for distribution in the United States.For international requests,an importation permit or an official letter from the appropriate government agency declaring that a permit is not required must be provided in advance of shipment.